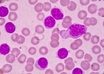

Targeting abnormal signals suggests novel method to treat a rare childhood blood disease
Newswise | Oct 11, 2018
New risk test for sepsis for heart patients
University of Leeds Health News | Oct 08, 2018
Viruses in blood lead to digestive problems
Washington University School of Medicine in St. Louis News | Oct 07, 2018
Duvelisib shows marked response, survival benefit in difficult-to-treat leukemia & lymphoma
American Society of Hematology News | Oct 06, 2018
Urine liquid biopsies could help monitor bladder cancer treatment
Cancer Research UK News | Sep 28, 2018
New blood test detects early-stage pancreatic cancer
Lund University News | Sep 19, 2018
What does it mean if your ESR is high?
Healthline/Medical News Today | Sep 18, 2018
Blood and brain fluid change first in Huntington's disease
University College London News | Sep 16, 2018
Findings could improve treatment for challenging acute leukemia in children
Newswise | Sep 14, 2018